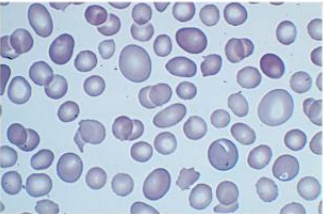
Enunciado 1570771-1

Foram encontradas 671 questões.
“O hemograma é o nome dado ao conjunto de avaliações das células do sangue que, reunido aos dados clínicos, permite conclusões diagnósticas e prognósticas de grande número de patologias. A introdução do hemograma na prática médica ocorreu em 1925 por meio de critérios estabelecidos pelo médico e farmacêutico alemão V.Schilling. Entre todos os exames laboratoriais atualmente solicitados por médicos de todas as especialidades, o hemograma é o mais requerido. Por essa razão reveste-se de grande importância no conjunto de dados que devem ser considerados para o diagnóstico médico, não se admitindo erros ou conclusões duvidosas. ”
Disponível em:
http://www.ciencianews.com.br/https://arquivos.infra-questoes.grancursosonline.com.br/arquivos/ACET/IMAGENS/Artigos_cientificos/Inter phemo.pdf
https://docplayer.com.br/52450257-Atlas-de-hematologia-eanalise-de-esfregacos-do-sangue-periferico.html
Observando a figura acima afirma-se que:
Provas
A Central de Materiais e Esterilização (CME) é a unidade funcional destinada ao processamento de produtos para a saúde dos serviços de saúde. Em 2017, na Resolução da Diretoria Colegiada (RDC) 15 (15 de março de 2012) estão dispostas as atribuições do enfermeiro, na CME. Diante desta RDC, cabe ao enfermeiro, EXCETO:
Provas
Considerando o processo de limpeza, desinfecção e esterilização, considere: É um processo de eliminação ou destruição de todos os microrganismos na forma vegetativa, independentemente de serem patogênicos ou não, presentes nos artigos e objetos inanimados. A destruição de algumas bactérias na forma esporulada também pode acorrer. Em relação ao enunciado, qual a afirmativa correta.
Provas
A Política Nacional de Humanização (PNH) tem por objetivo colocar em prática os princípios do SUS no cotidiano dos serviços de saúde, promovendo mudanças no gerir e cuidar, além de estimular a comunicação entre gestores, trabalhadores e usuários para construir meios coletivos de enfrentamento de relações de poder que geram atitudes e práticas desumanas que inibem a autonomia dos profissionais e usuários do sistema de saúde. Para isso, apresenta as seguintes diretrizes:
Provas
De acordo com a resolução Cofen-358/2009, “ consiste em um processo deliberado, sistemático e contínuo de verificação de mudanças na pessoa, família ou coletividade humana em dado momento do processo saúde-doença, para determinar se as intervenções de enfermagem alcançaram os resultados esperados”.
A descrição acima se refere a qual etapa do processo de enfermagem?
Provas
“As boas práticas e sistematização da fase pré-analítica, principalmente no processo de coleta da amostra, evita uma série de erros, retrabalhos e desperdícios de amostras e de reagentes, evitando danos aos pacientes e também ao laboratório. ”
Disponível em:
https://kasvi.com.br/coleta-de-sangue-boas-praticas/.
Sobre os cuidados que se deve ter na coleta de material biológico pode-se afirmar:
Provas
“As técnicas de imobilização e remoção de vítimas de trauma têm vindo a ser modificadas ao longo dos anos com o objetivo de estabelecer o conjunto de procedimentos mais adequados que maximize a segurança na mobilização das vítimas de trauma”.
Disponível em: https://www.inem.pt/wpcontent/uploads/2017/06/T%C3%A9cnicas-de-Extra%C3%A7%C3%A3o-eImobiliza%C3%A7%C3%A3o-de-V%C3%ADtimas-de-Trauma.pdf.
Uma das técnicas de imobilização é a estabilização manual da cabeça. A cabeça é estabilizada de forma cuidadosa, alinhando-a em posição neutra, a não ser que haja contraindicação. É contraindicação, exceto:
Provas
Atualmente, os acidentes se multiplicam de forma assustadora. Os episódios traumáticos, as intervenções cirúrgicas e o tratamento de patologias complexas são inerentes ao dinamismo sempre crescente da civilização moderna. Em relação as fraturas, assinale a alternativa CORRETA.
Provas
“O Programa Saúde da Família foi implantado no Brasil pelo Ministério da Saúde em 1994. É conhecido hoje como "Estratégia de Saúde da Família", por não se tratar mais apenas de um "programa".
Disponível em: http://www.saude.gov.br/.
Assinale o conceito correspondente à Estratégia de saúde da família:
Provas
“O diagnóstico da doença de Chagas suspeita-se pela epidemiologia e/ou pela clínica e confirma-se pela presença de anticorpos anti-Trypanosoma cruzi, ou seja, pela sorologia realizada no Laboratório clínico. O médico experiente, diante de um paciente procedente de região endêmica para tripanossomiase americana e que apresenta cardiopatia e/ou megaesôfagomegacólon, apenas confirma a etiologia chagásica solicitando os exames sorológicos. Em outras circunstâncias, o médico recebe um indivíduo que não expõe queixas específicas, porém exibe o resultado de exame sorológico positivo exigido para admissão em emprego ou por ocasião de doação de sangue. Os exames laboratoriais indicados para o diagnóstico de doença de Chagas vão depender da fase da doença em que o paciente se encontra: fase aguda ou crônica. ”
Disponível em:
http://books.scielo.org/id/nf9bn/pdf/dias-9788575412435-07.pdf .
Sobre o diagnóstico laboratorial da doença de Chagas marque a alternativa CORRETA:
Provas
Caderno Container